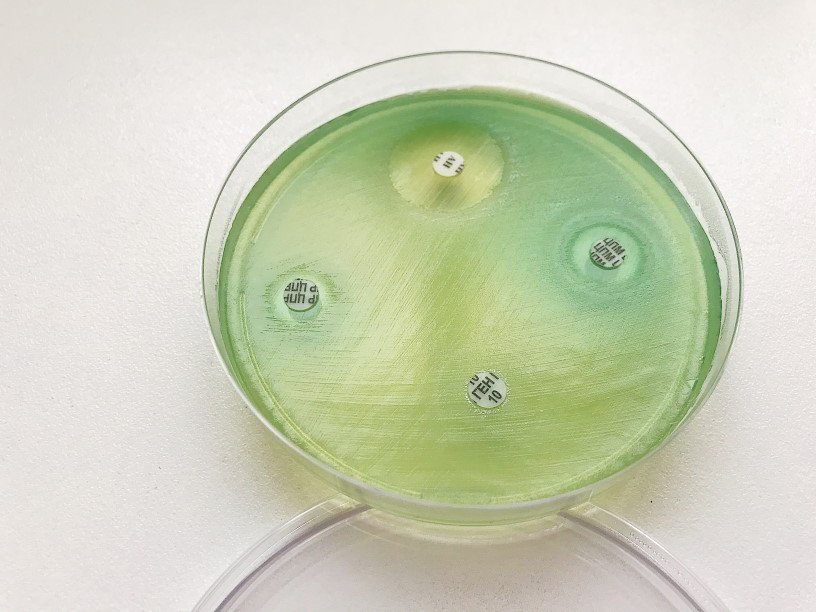

Екатерина Беленко: Промикробы: Антикиллер
ВОЗ называет сегодня устойчивость к антибиотикам одной из главных опасностей для глобального здравоохранения. Например, все труднее становится лечить пневмонию, туберкулез, гонорею и сальмонеллез. Ожидается, что к 2050 году супербактерии убьют людей больше, чем рак, — 10 млн человек. Сейчас из-за устойчивости к антибиотикам ежегодно умирает 700 тысяч человек.
⠀
Устойчивость к противомикробным препаратам является неизбежным последствием назначения антибиотиков. Какие бы инфекции мы ни лечили, бактерии, являющиеся частью нашей обычной флоры, всегда подвергаются воздействию, а выжив под натиском антибиотиков, они просто разрабатывают более хитроумные способы для того, чтобы устоять под воздействием самых сложных и самых современных антимикробных препаратов. Что же делать? Конечно, разрабатывать новые антибиотики, пытаться опережать в гонке вооружений. Однако необходимы не только научные открытия, но и экономические стимулы.
⠀
Инвестиции в антибиотики приносят низкую прибыль, так как они принимаются в течение небольшого периода времени и предназначаются для лечения определенных болезней. В отличие от них, лекарства, предназначаемые для лечения хронических болезней — таких как, например, высокое кровяное давление, — принимаются ежедневно в течение всей оставшейся жизни пациента.
⠀
Одним из микроорганизмов, сильно угрожающих нам множественной устойчивостью к противомикробным препаратам, является синегнойная палочка. Pseudomonas aeruginosa благодаря сигнальным молекулам, формирующим чувство кворума, могут принимать общие решения для приспособления к особенностям среды и собственной защиты. Это делает их особо устойчивыми даже к большим дозам антибиотиков. Формируемая таким способом биоплёнка защищает целую колонию от попадания в неё вредных веществ, в том числе и антибиотиков, сильно затрудняя лечение.
⠀
Согласно некоторым исследованиям, определенные вещества, содержащиеся в чесноке, оказывают ингибиторное воздействие на социальное поведение Pseudomonas aeruginosa, тем самым делая лечение более эффективным, помогая антибиотикам проникнуть к клеткам бактерии через биопленку, которая либо хуже, либо совсем не формируется. Наши бабушки не ошибались!
⠀
Забавно, что предок всех современных антибиотиков был создан благодаря синегнойной палочке. Во время Крымской войны французские хирурги обнаружили, что гнойные раны некоторых солдат окрашивают перевязку в аквамариновый цвет. Но сам этот пигмент обнаружили только в 1869 году микробиолог Рудольф Эммерих и хирург Оскар Лёв. Они заметили, что зелёные бактерии ингибируют рост других микробов. Тогда они вырастили несколько партий синегнойной палочки и использовали супернатант — надосадочную жидкость — как лекарство, но, правда, с переменным успехом. Выходит, что полученный фермент пиоцианаза был первым антибиотиком, а сейчас Pseudomonas aeruginosa — гроза всех антибиотиков и врачей заодно. Такая вот микробная ирония.